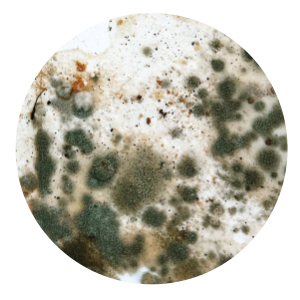

by Medklinn Air+Surface Sterilizers
by Medklinn Air+Surface Sterilizers

Medklinn’s sterilizing technology provides the highest standards of hygiene without the use of harmful chemicals.
 
With the Air+Surface Sterilizers operating continuously, you can experience the highest level of hygiene and safety.
Medklinn’s sterilizing technology provides the highest standards of hygiene without the use of harmful chemicals.
 
With the Air+Surface Sterilizers operating continuously, you can experience the highest level of hygiene and safety.

*Microbiology Test available here.
Sustainable and Chemical-free
Sustainable and Chemical-free
Patented Cerafusion™ Technology, the world’s first, replicates nature in the sterilization process by producing Active Oxygen consisting of controlled levels of ozone and negative ions. Active Oxygen eliminates 99.9% of viruses, bacteria, allergens, mould, bad odour and other toxic substances.

Patented Cerafusion™ Technology, the world’s first, replicates nature in the sterilization process by producing Active Oxygen consisting of controlled levels of ozone and negative ions. Active Oxygen eliminates 99.9% of viruses, bacteria, allergens, mould, bad odour and other toxic substances.



How Safe is Safe?
Medklinn's Cerafusion™ Sterilization Technology offers a higher level of protection and safety when compared to general sanitazation practices, which is important now during this challenging time.

Medklinn's Cerafusion™ Sterilization Technology offers a higher level of protection and safety when compared to general sanitazation practices, which is important now during this challenging time.


 


The Versa series is versatile, light and easy to carry around. Versa 45 which is rated to cover up to 450 square feet comes in Classic Titanium.
The Versa series is versatile, light and easy to carry around. Versa 45 which is rated to cover up to 450 square feet comes in Classic Titanium.

Protection On the Move
Protection On the Move
Sculptured to complement modern car interiors, the Autoplus is designed with a power dial to allow easy control of Active Oxygen to suit different vehicle sizes and conditions. The versatile Autoplus Docking provides USB connection capability and an extra USB port.

Sculptured to complement modern car interiors, the Autoplus is designed with a power dial to allow easy control of Active Oxygen to suit different vehicle sizes and conditions. The versatile Autoplus Docking provides USB connection capability and an extra USB port.